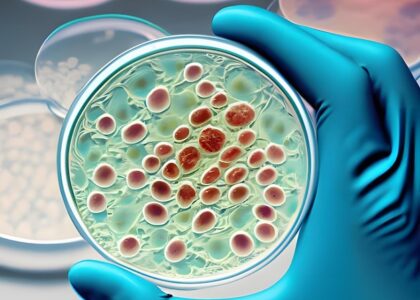
Cell Regeneration Medicine Market

Cell Regeneration Medicine Market Poised for Explosive Growth, Set to Exceed USD 300 Billion by 2035
The global Cell Regeneration Medicine market is on a trajectory of phenomenal growth, with a


The global Cell Regeneration Medicine market is on a trajectory of phenomenal growth, with a
The global cell regeneration medicine market is on an unprecedented trajectory of growth, poised to
The global cell regeneration medicine market is poised for exponential growth, riding high on a

The Cell Regeneration Medicine Market is a rapidly growing field that aims to develop and
According to Future Market Insights’ newly released Cell Regeneration Medicine Market analysis report, the global market valuation